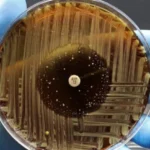

Живые биороботы из клеток человека заживляют нервные ткани
Вы только задумайтесь: последние десять лет учёные всерьёз взялись за создание живых машин. Не железок с моторчиками, а крошечных существ из плоти и клеток. Звучит как сценарий научной фантастики, но цель тут предельно земная и благородная — научиться чинить человеческое тело изнутри. И, кажется, у нас намечается прорыв. Американская команда исследователей объявила о создании биороботов из наших с вами клеток, которые способны помогать заживлять нервы.
Помните 2020-й? Тогда мир впервые услышал про ксеноботов. Их сделали из клеток кожи лягушки, и это было нечто невероятное: они плавали в жидкости, толкали грузы, работали сообща и даже залечивали свои «раны». А год спустя те же ребята из Университета Тафтса и Вермонта показали улучшенную версию, которая умела самовоспроизводиться. Согласитесь, от лягушачьей кожи до человеческой ткани — дистанция огромного размера. Но именно её и решили сократить учёные.
И вот тут возникает главный вопрос: а можно ли сделать такое же, но из наших, человеческих клеток? Чтобы организм не отторгал помощника, а принимал его за своего? Та же команда взялась за проверку этой идеи, использовав эпителиальные клетки бронхов человека. Их цель была амбициозной — создать биороботов, совместимых с нашим телом для будущей медицинской помощи.
Живые «мосты» для починки ран
Новых созданий назвали антроботами. Это крошечные шарики диаметром с пылинку — от 30 до 500 микрометров. Представьте себе: вся их поверхность покрыта ресничками, как подошва какой-нибудь гусеницы. Только эти реснички работают как вёсла, позволяя роботам шустрить в воде со скоростью до 50 микрометров в секунду. «Каждый из них начинается с одной-единственной клетки из лёгкого взрослого человека, — объясняют исследователи. — Две недели культивации в особой среде — и она превращается в подвижную многоклеточную машину». Живут такие создания в лаборатории до полутора месяцев и, что важно, полностью разлагаются без следа.
Антроботы, как люди, все разные. Учёные выделили три основных типажа: есть малютки, есть покрупнее, с ресничками, торчащими в разные стороны, формой то ли шарики, то ли эллипсы. И каждый тип двигается по-своему: кто-то бегает по кругу, кто-то — по прямой, а кто-то выделывает немыслимые пируэты. И это открывает потрясающую возможность: такие роботы могут путешествовать по живой человеческой ткани, выбирая самый удобный маршрут.

Но самое захватывающее случилось, когда учёные решили проверить, как антроботы поведут себя на настоящей ране. Взяли ткань с повреждёнными нейронами человека. Сначала биологи собрали несколько антроботов в кучку, чтобы они слиплись в некое подобие «супербота». А затем поместили эту конструкцию на повреждённый участок.
И тут началась магия. «Мы просто положили этих «суперботов» на разрыв ткани, а через 72 часа увидели, как собственная ткань начала активно отрастать, — описывают авторы в своей статье. — Прямо под нашими живыми мостиками из роботов образовалась новая ткань, соединившая края раны». Представляете? Там, где не было суперботов, заживления не происходило. А где были — ткань восстанавливалась.

Конечно, сразу возникает вопрос: а как это поможет обычным людям? Ведь до клиник ещё далеко. Но исследователи смотрят в будущее с оптимизмом. Самое прекрасное в антроботах — их можно сделать из клеток самого пациента. «Это значит, что организм не будет воспринимать их как чужаков, — поясняют учёные. — Никакого воспаления, никакой иммунной атаки. Идеальный персональный доктор». Представьте: такого робота можно запустить в сосуд, чтобы он растворил бляшку, или отправить с лекарством точно в цель, или заставить восстанавливать клетки спинного мозга после травмы.
Что дальше? Команда планирует экспериментировать с другими типами клеток и искать у антроботов новые, ещё не открытые таланты. Ведь если безмозглые клетки бронхов вдруг научились лечить нервы, кто знает, на что ещё способны наши собственные тела? Мы только начинаем это выяснять.